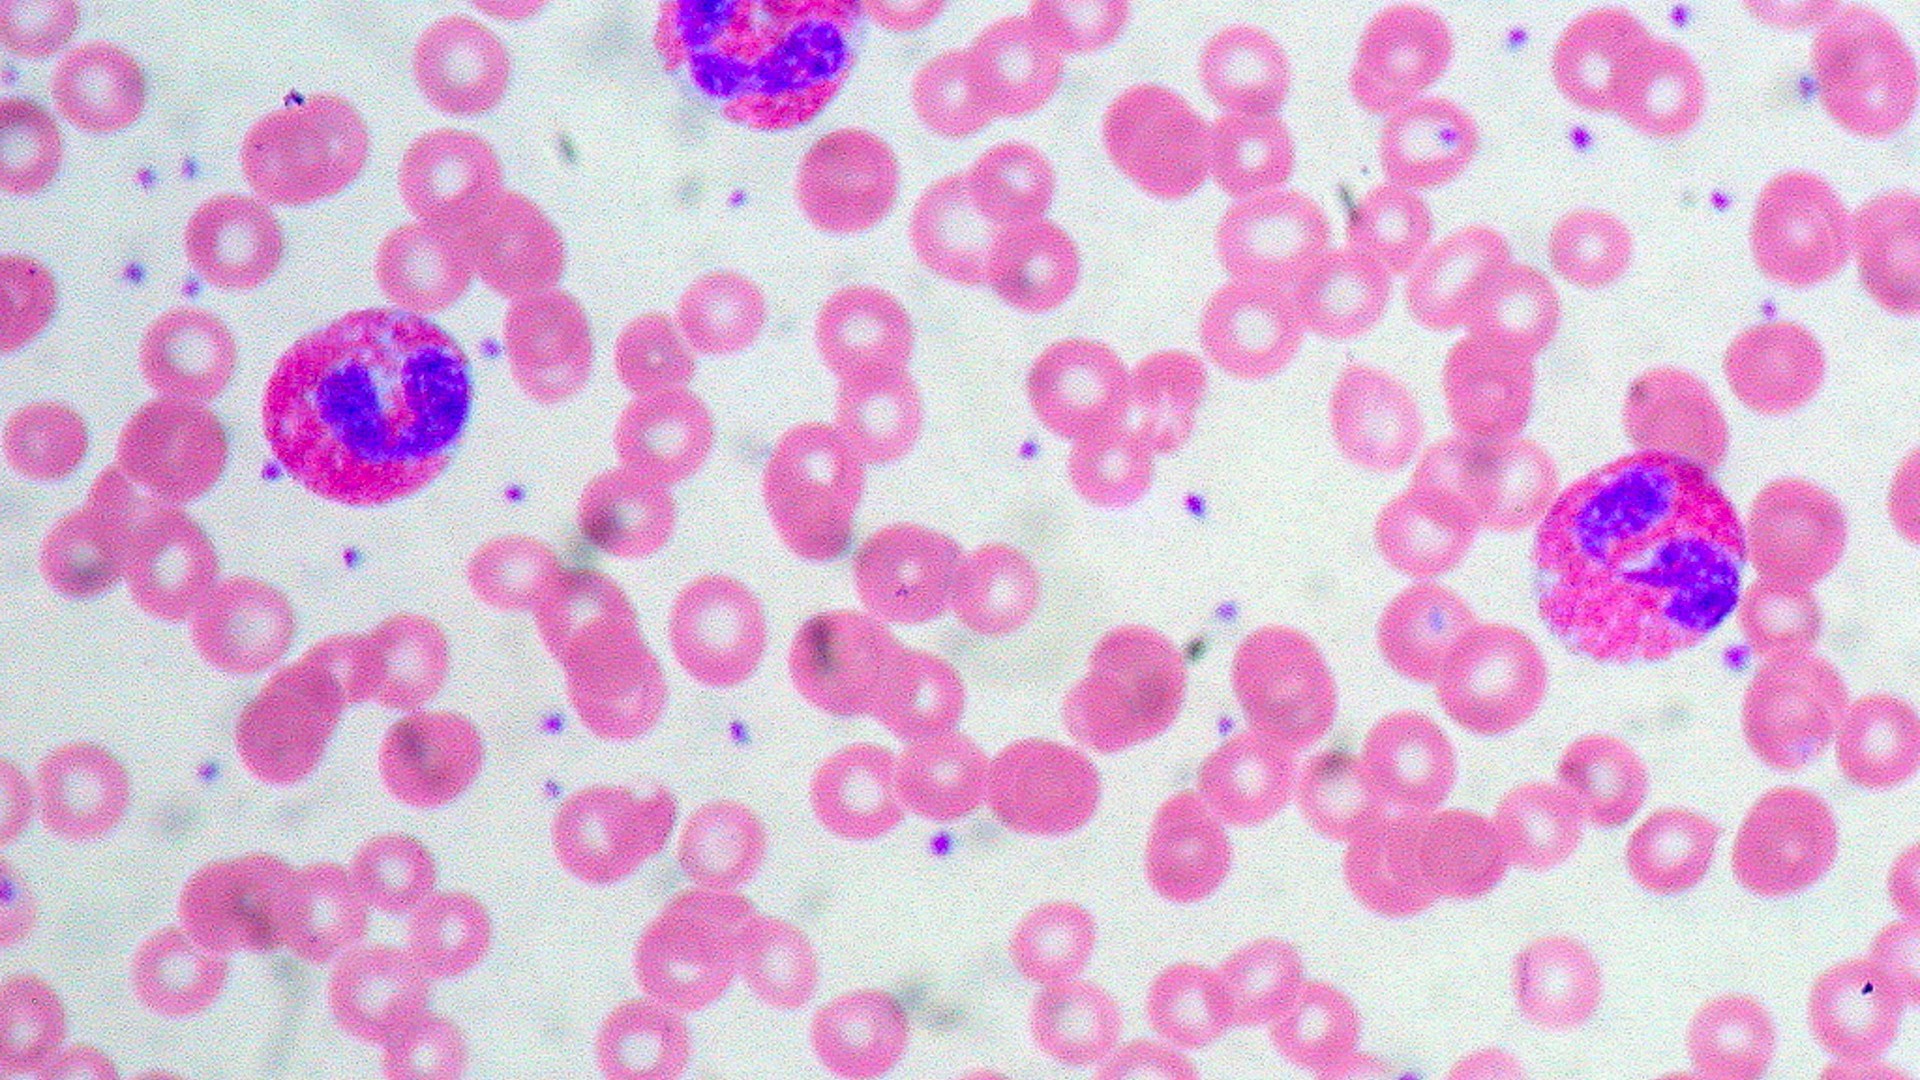

Denominados como una clase de leucocitos o glóbulos blancos, los eosinófilos hacen parte del sistema inmunológico innato presentando una serie de proteínas que tienen a cargo la labor de apoyar al organismo en la lucha contra las enfermedades. Fueron descritos por primera vez en 1879 por Paúl Ehrlich, quien decidió darles este nombre debido a que se teñían intensamente a partir de colorantes ácidos como por ejemplo la eosina.
Por tratarse de células fagocitarias, los eosinófilos intervienen en la acción contra infecciones virales, bacterias y parásitos, esto gracias a que rodean con su membrana estas partículas para posteriormente desintegrarlas. Puesto que son un componente presente tanto en la sangre como en los tejidos, veremos a continuación con algo más de detalle, en dónde se encuentran los eosinófilos más exactamente.
Dónde están y qué hacen los eosinófilos
Representando del 1 al 3% de los leucocitos que se encuentran en la sangre, los eosinófilos son generados por mitosis de las células precursoras en la médula ósea donde permanecen unos cuatro días. De ahí en adelante pueden ser encontrados en el timo, tracto gastrointestinal, ganglios linfáticos, en el bazo, en el tracto respiratorio y en el urinario caracterizándose por presentar un tamaño de 10 a 15 micras de diámetro y por estar compuestos de gránulos lisosomales primarios, gránulos los densos pequeños y gránulos secundarios.
Además de responder a patógenos de una manera genérica, entre sus funciones se encuentra el ser mediadores de las respuestas alérgicas, incluyendo el asma. Los eosinófilos no solo reconocen a otros organismos invasores, responden y los destruyen sin que exista espacio para la adaptación, lo cual algunas veces no logra garantizar una inmunidad a largo plazo; se sabe también que regulan inflamaciones permitiendo una respuesta inmunológica mucho más acertada.
Los valores de eosinófilos en sangre
Ante un análisis de sangre, lo propio es que su conteo no supere la cifra de más de 500 células por microlitro de sangre, pues se tendría como resultado a la eosinofilia el nombre con el que se reconoce médicamente a los eosinófilos altos y que demuestra la presencia de parásitos o reacciones alérgicas, además de un posible contacto con tóxicos, enfermedades autoinmunes, perturbaciones endocrinas y tumores.
En cuanto a los eosinófilos bajos, es una condición que se reconoce cuando el conteo es inferior a 50 células por micro litro de sangre, recibiendo el nombre de eosinopenia; las infecciones bacterianas, el VIH, el lupus y el estrés son sus causas más inmediatas.